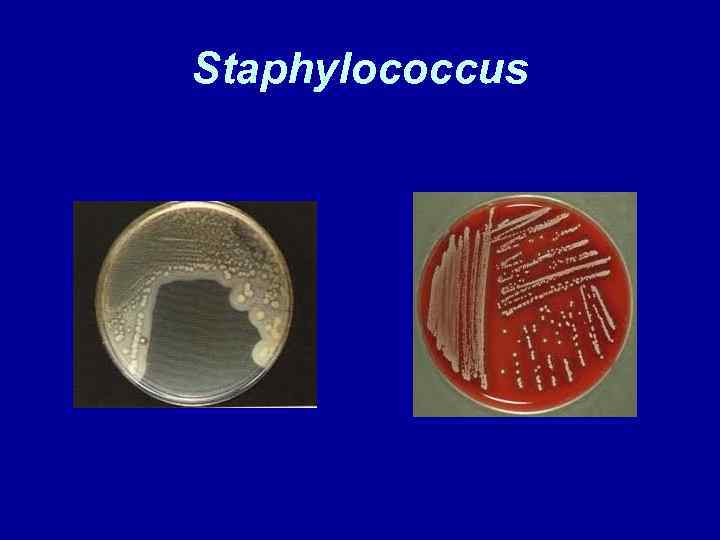

Раневая инфекция.ppt
- Количество слайдов: 48

Раневая инфекция Лекция профессора Бойченко М. Н.

Неферментирующие бактерии • Группа грамотрицательных бактерий, которые не ферментируют глюкозу, а разлагают ее оксидативным путем • Являются ведущими возбудителями госпитальной инфекции • Наиболее значимым механизмом антибиотикорезистентности – эффлюкс (мембранные системы вызывают выброс антибиотика)

Неферментирующие бактерии • Характеризуются наличием сигнальной системы «чувства кворума» , которая отвечает за контроль продукции факторов патогенности, что обеспечивает бактериям преодоление защитных сил макроорганизма • Не продуцируют индол

Неферментирующие бактерии • Тест ХЬЮ-ЛЕЙФСОНА выявляет механизм утилизации глюкозы. Производят засев в 2 пробирки со специальной средой с глюкозой, одну из которых заливают маслом дл создания анаэробных условий

Род Вид признаки инфекция Pseudomonas P. aeruginose Цветочный запах, среда окрашивается в зеленый цвет Ожоговая, раневая мочевого тракта инфекции, пневмонии, сепсис Acinetobacter A. baumanii Оксидазонегат Пневмония, ивный, сепсис, раневая инфекция Burkholderia B. cepacia Устойчив к полимиксину, пигментообра зование от желтого до красного Сепсис, бронхит,

Pseudomonas aeruginosa • К роду Pseudomonas относят возбудителей, обитающих в окружающей среде и при определенных условиях способных вызвать заболевание у человека. Наиболее патогенной бактерией является Pseudomonas aeruginosa (синегнойная палочка), которая представляет грамотрицательную подвижную палочку широко распространенную в


Pseudomonas aeruginosa • Микроб не образует спор, формирует капсулу, имеет пили 4 типа, которые участвуют в формировании биопленки на медицинских инструментах. Pseudomonas aeruginosa обладает оксидазной активностью, сахара окисляет, но не ферментирует с образованием кислот и газа: обладает протеолитической активностью: вырабатывает пигмент пиоцин, имеющий сине-зеленый цвет и бактериоцины.


Pseudomonas aeruginosa • Источником Pseudomonas aeruginosa могут быть любые предметы: умывальные раковины, водопроводные краны, медицинский инструментарий. Культуры синегнойной палочки сохраняют жизнеспособность даже в растворах дезинфицирующих веществ( растворе фурациллина), предназначенных для хранения катетеров и медицинских инструментов, промывания ран. Это связано с ограниченной потребностью микроба в питательных веществах.

Pseudomonas aeruginosa • Pseudomonas aeruginosa вырабатывает токсины(цитотоксин А и экзотоксины S), ферменты патогенности: гемолизины, эластазу, фосфолипазу С, нейраминидазу; обладает секреторной системой 3 типа. Микроб проникает в организм обычно через поврежденные ткани. Прикрепляясь, микроб заселяет раневую ил ожоговую поверхности, слизистые оболочки и размножается. При отсутствии у человека иммунной реакции, процесс принимает генерализованное течение с образованием вторичных гнойных очагов инфекции.

Pseudomonas aeruginosa • Pseudomonas aeruginosa вызывает гнойно -воспалительные заболевания различной локализации: раневую и ожоговую инфекции, инфекции мочевыводящей системы, менингиты, пневмонию и др. Тяжелыми осложнениями являются синдром диссеминированного внутрисосудистого свертывания, шок, респираторный дистресс-синдром

Acinetobacter • Acinetobacter sp. -мелкие грамотрицательные, могут быть грамвариабельными, коккобациллы, неподвижные, бескапсульные. Оксидазонегативные, каталазопозитивные. • Обитают в окружающей среде и обладающие природной устойчивостью к большинству антибиотиков.


Acinetobacter • Возбудитель колонизирует предметы в местах высокой влажности и вызывает вспышки мультирезистентных инфекций, протекающих в виде пневмоний, менингита и инфекций мочевыводящих путей. В группу риска входят пациенты, принимающие антибиотики, у которых установлены катетеры.

Burkholderia cepacia • Грамотрицательная палочка. Обладающая полярными жгутиками, пилями • Обитает в воде, почве, в корнях растений. • Обладает способностью разлагать оксические компоненты пестицидов. Репрессирует почвенные патогены


Burkholderia cepacia • Глюкозу разлагает по пути Этнера. Дудорова, в этом процессе принимает также пентозный цикл • В качестве источник углерода может использовать трихлорфеноксиуксусную кислоту

Burkholderia cepacia • Продуцирует индуцибельную беталактомазу. Помимо формирования устойчивости к антибиотику использует продукты его расщепления как источник углерода

Burkholderia cepacia • • • ФАКТОРЫ ПАТОГЕННОСТИ: 1. липаза 2. металлопротеаза 3. серинпротеаза 4. способность формировать биопленку


Burkholderia cepacia • Липаза секретируется по 2 пути секреции, • синтез регулируется чувством кворума • Принимает участие в инвазии клеток легких

Burkholderia cepacia • Металлопротеаза поражает легочную ткань ( протеолитически ативна против белков экстрацеллюлярного матрикса легких) • Серинпртеаза – ключевой фактор внутриклеточной инвазии

Burkholderia cepacia • Образование биопленки зависит от прдукции экзополисахарида (цепацина), который стабилизирует трехмерную архитектонику • ЛПС индуцирует воспалительный ответ

Burkholderia cepacia • Вызывает SWAMP FOOT –кожное повреждение стопы,

Staphylococcus spp • Впервые идентифицированы в 1880 г английским хирургом Огстоном в гное абсцесса коленного сустава • Род Staphylococcus включает 32 вида, из которых клиническое значение имеют 8 видов, среди них: S. aureus, S. saprophyticus, S. epidermidis, S. haemolyticus

Staphylococcus spp • Классификация проводится по генотипическим и биохимическим признакам • Клинически значимая классификация проводится по отношению продукции плазмокоагулазы (соа) • S. aureus, -коагулазоположителен • S. saprophyticus, S. epidermidis, S. haemolyticus - коагулазоотрицательны


Staphylococcus • Учитывается устойчивость к новобиоцину (S. saprophyticus) и полимиксину (S. aureus, S. epidermidis) • Существует внутривидовая идентификация S. aureus по фаготипам, что используется для рбнаружения источника инфекции и путей передачи

Staphylococcus • Стафилококки растут на простых питательных средах, но в результате галофильности могут расти при концентрации Na. Cl в среде до 15%, поэтому элективными средами являются ЖСА, среда № 10 (маннит солевой агар(
Staphylococcus

Staphylococcus • Биохимически активны. Продуцируют каталазу, ферментируют сахара, расщепляют аминокислоты. По биохимическим свойствам проводится внутриродовая идентификация. • Факультативные анаэробы • Обладают пигментами, которые являются антиоксидантами • Коагулазопозитивные стафилококки рассматриваются, как наиболее патогенные

Staphylococcus • Коагулазопозитивные стафилококки рассматриваются, как наиболее патогенные (S. intermedius, S. aureus)

S. aureus • S. aureus входит в состав микрофлоры кожи и верхних дыхательных путей. Его присутствие не означает наличия заболевания, • Вызывает гемолиз, ферментирует маннит

S. aureus • Инфицирует кожу, слизистые оболочки, через их повреждения • Вызывает развитие карбункулов, фурункулов, маститы, остеомиелиты, эндокардит, синдром «ошпаренной кожи у новорожденных» , сепсис, синдром токсического шока, пищевую интоксикацию

S. аureus • Факторы патогенности: • 1. ферменты: коагулаза, гиалуронидаза, лецитовителлаза, ДНК-аза, фибринолизин, лизоцим (антогонизм в биоцинозе), нейраминидаза • 2. токсины: эксфолиативный токсин ( действующее начало протеаза вызывает слущивание кожи, участвует в развитии синдрома «ошпаренной кожи» ; •

S. aureus • Токсин синдрома токсического шока. Является суперантигеном. Эффект проявляется лихорадкой, сыпью, гипотензией, возникает в результате применения интравагальных тампонов • Лейкоцидин –связан с развитием некротической пневмонии у детей. Синтез обусловлен бактериофагом

S. aureus • Энтеротоксины (А-F) термостабильные гистотоксины, устойчивые к протеолитическим ферментам являются суперантигенами- вызывают поликлональную активацию Тлимфоцитов с последующей гиперсекрецией цитокинов и вторичной интоксикацией.

S. aureus • 3. Белок А Связывает Fc фрагменты антитела, блокируя опсонизацию фагоцитоза. • Используется при создании диагностикумов для реакции ко-агглютинации • 4. Факторы, обеспечивающие персистенцию (антилизоцимная активнсть, антикомплементарная активность)

Staphylococcus spp • Исследования последних лет показали, что коагулазоотрицательные стафилококки, которые долгое время считались нормальными обитателями кожи и слизистых, проявляют себя как возбудители внутрибольничных инфекций. При том выделенные штаммы содержат R-плазмиды и продуцируют бета-лактамазу.

Staphylococcus spp • В этом случае эпидермальный стафилококк является источником Rплазмиды для приобретения устойчивости золотистым стафилококком. Также известно, что 90%; госпитальных штаммов S. aureus, обладают резистентностью к пенициллину, в результате продукции бета-лактамазы.

Staphylococcus spp • Наряду со штаммами, продуцирующими бета-лактамазу, в стационарах циркулируют метициллинрезистентные стафилококки. Такие штаммы резистентны ко всем бета-лактамным препаратам, включая цефалоспорины, а также могут быть одновременно устойчивы к эритромицину, тетрациклину, клиндомицину, левомицетину и аминогликозидным

MRSA • Резистентность к метициллину опосредована mec-опероном, который кодирует синтез пенициллин связывающего белка, обладающий низким аффинитететом к беталактамазе и способностью связываться с бета-лактамными антибиотиками: пенициллинами, цефалоспоринами и карбопинемами, что создает формирование резистентности к беталактамам

S. saprophyticus • S. saprophyticus является возбудителем в 20% инфекции мочевыводящей системы. Он входит в состав микрофлоры женских половы органов. Он обладает устойчивостью к новобиоцину, продуцирует уреазу, в мочевом тракте под влиянием мочевины формирует капсулу. Не расщепляет маннит, не вызывает гемолиз

S. haemolyticus • Занимает второе место после S. epidermidis развитии оппортунистической инфекции. • Входит в состав микрофлоры кожи • Обладает выраженной биохимической активностью: утилизирует глюкозу мальтозу, сахарозу, глицерин, продуцирует каталазу, негативен в отношении оксидазы, уреазы, коагулазы

S. haemolyticus • Продуцирует полисахаридную капсулу, которая обеспечивает резистентность в комплемент-опосредованному фагоцитозу • Образует биопленку, которая обеспечивает резистентность к антибиотикам и к формированию персистирующей инфекции

S. haemolyticus • Образование биопленки не связано в отличии от других коагулазонегативных стафилококков с продуктом гена ica. • На образование биопленки влияет глюкоза, белок и внеклеточная ДНК • Некоторые штаммы продуцируют энтеротоксин

S. haemolyticus • Идентификация проводится по биохимическим свойствам • Обладает наибольшей устойчивостью к антибиотикам среди коагулазонегативных стафилококков • Вызывает катетер связанную инфекцию, инфекции, связанные с имплантантами, эндокардит, сепсис
Раневая инфекция.ppt